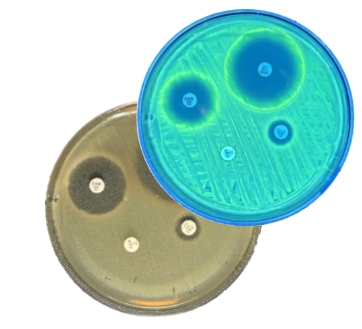
Capture d’écran_10-11-2025_145650_www.canva.com

Développement d’un dispositif de diagnostic rapide contre la résistance aux antibiotiques
Molsid développe MICAST, un dispositif de diagnostic médical de nouvelle génération permettant la détection par fluorescence de la résistance aux antibiotiques, offrant ainsi un antibiogramme rapide pour une adaptation précoce des traitements antibiotiques.
Ce projet promet non seulement de sauver des vies et de réduire les coûts de santé, mais aussi de contribuer à la sauvegarde de l’arsenal actuel d’antibiotiques et à la réduction de la dissémination des bactéries résistantes dans l’environnement.
▪️Le contexte
- Le projet MICAST s’attaque à la menace mondiale de la résistance aux antimicrobiens en révolutionnant la méthode de réalisation des antibiogrammes, les tests diagnostiques de sensibilité aux antibiotiques.
- Molsid développe une technologie innovante de biotraceurs fluorescents qui :
- Identifie rapidement et automatiquement les résistances aux antibiotiques à partir d’une culture bactérienne
- Réduit les délais d’analyse de 48 heures à 28 heures, et jusqu’à seulement 4 heures pour les cas critiques de septicémie
- Afin de pouvoir tester et valider ce procédé en vue de futurs essais cliniques, Molsid avait besoin très rapidement d’un détecteur UV intégrant un incubateur, à température régulée, incluant caméra et logiciel d’analyse d’image.
▪️ L’objectif
- Améliorer le temps de diagnostic et optimiser la prescription d’antibiotiques
- Offrir le meilleur rapport vitesse/coût, en faisant gagner une journée sur les résultats et s’intégrant facilement aux flux de travail des laboratoires de microbiologie
▪️ La solution
- Kickmaker a développé le premier prototype fonctionnel (POC) du dispositif, intégrant un système d’imagerie et d’analyse automatique des réactions à l’intérieur des boîtes de Petri.
Ce POC combine:- incubation contrôlée
- capture d’images de haute précision
- analyse logicielle des halos d’inhibition autour des disques antibiotiques
Développements techniques
En tant que partenaire technique, Kickmaker a assuré l’ensemble de la conception de ce projet innovant :
- Conception d’un incubateur intégré à température régulée pour cultures bactériennes.
-
Intégration d’un système optique adapté à la détection fine des halos sur boîte de Petri.
-
Développement logiciel pour l’analyse d’image automatisée des tests antibiogrammes.
-
Réalisation du POC complet validé en laboratoire de microbiologie.
- Prototypage rapide: sélection et intégration des bonnes technologies en un mois et demi pour aider le client à respecter les essais cliniques.
- Résultat : POC robuste et entièrement fonctionnel développé dans le temps imparti, ayant permis à Molsid de réussir les jalons des essais cliniques prévus.
Expertise de Kickmaker
Grâce à notre expertise en mécatronique et prototypage rapide, nous avons permis à Molsid de :
-
Structurer et assembler les différentes fonctions du dispositif dès les premières phases du développement.
-
Accélérer la création d’un prototype fonctionnel, en intégrant incubation, optique et traitement d’image.
-
Poser les bases d’une industrialisation future, en anticipant les contraintes de fiabilité et d’intégration.
Ils témoignent
“Ce fut un réel plaisir de collaborer avec Kickmaker sur ce projet innovant. Leur expertise et leur connaissance approfondie des exigences propres aux analyses biomédicales ont permis de finaliser ce projet en un temps record d'un mois et demi. Ce succès témoigne de leur maîtrise et de leur engagement.”
Stéphane GavoilleCEO - Molsid
“Pour relever le défi de délais de validation très courts, nous avons misé sur l’intégration de briques technologiques éprouvées. La collaboration étroite avec les biologistes de Molsid a permis de répondre parfaitement aux besoins métier.
Fabien MunozProject manager – Kickmaker
Cette synergie a été déterminante pour le succès du projet.”
Découvrez l’expertise de Kickmaker
Innovation.
01. Stratégie
de conception et d’industrialisation.
Définissez les possibilités inhérentes au développement de vos produits et les schémas industriels associés.
Anticipation.
03. Gestion
du cycle de vie produit.
Suivi de production, contrôle qualité et suivi de la vie série de votre produit.